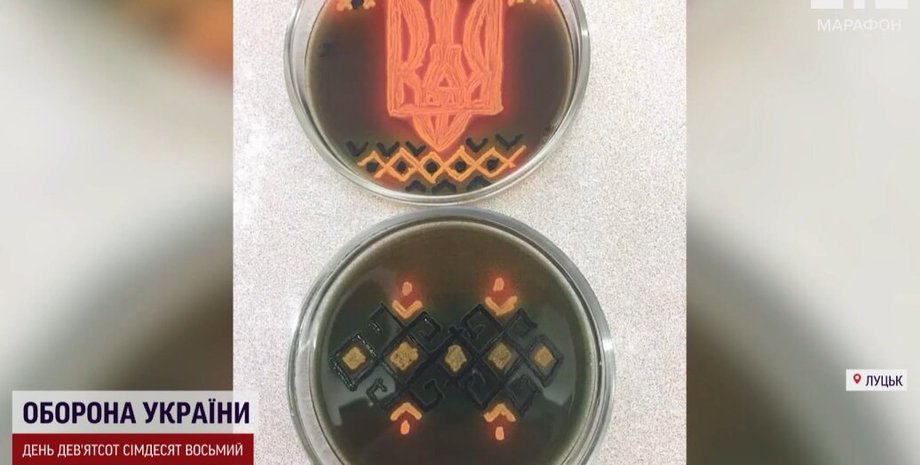
новини луцька, жінка вишиває бактеріями, вишивання, стафілококи вишивка

Замість ниток — стафілококи й ентерококи: на Волині жінка "вишиває" бактеріями (відео)
Замість полотна вишивальниця використовує хромогенне середовище, а різні бактерії відповідають за різні кольори. Жінка спочатку малює ескіз, а вже потім береться за мікроорганізми, які мають лягати чітко по лініях.
Лікарка-мікробіолог із Волині перемогла на всеукраїнському конкурсі мікробіологів. Вона вразила суддів своїми "вишитими" роботами, де замість муліне використала бактерії. Про це розповідає ТСН.
Так, мікробіологиня Руслана Таранюк, яка керує відділенням мікробіології у одному з медичних закладів Луцька, вразила журі своєю оригінальністю. Вона створила кольорову вишивку мікроорганізмами.
Замість полотна вишивальниця використовує хромогенне середовище, а замість ниток — бактерії. Кожна відповідає за певний колір. Наприклад, для чорного кольору науковиця використовує збудник сальмонели.
"Насичений жовтий — це золотий стафілокок, зелений – це ентерокок", — розповіла про свою роботу науковиця.
Такі незвичні вишивки — результат довгих років досліджень, оскільки пані Руслана з колегами визначають збудника хвороб вагітних і немовлят та ідентифікують групу бактерій, завдяки чому лікарі підбирають для дитини найбільш дієвий антибіотик.
Те, що у "вишивці" здається блідо-рожевим, у реальному житті загрожує немовлятам менінгітами та пневмоніями.
Колеги відзначають ювелірну роботу своєї керівниці.
"Руслана Ярославівна залишалася навіть у свій вільний час. Це такі виважені рішення мають бути, точність рухів", — каже бактеріологиня Ірина Куровець.
Як розповіла жінка, ідея створити "вишивку" бактеріями виникла в неї давно.
"У нас вишиває кілька поколінь, вишивала прабабуся, вишивали бабусі, дві мої доньки", — каже Руслана Таранюк.
Науковиця пояснює, що працювати з мікроорганізмами нелегко, оскільки вони "неслухняні".
Вона спочатку малює ескіз, а вже потім береться за мікроорганізми, які мають лягати чітко по лініях. І це дуже клопітка робота.
"Наша рука не повинна здригнутися, щоб чітко та прицільно взяти одну колонію", — каже науковиця.
Кольори проявляються не одразу — спершу це просто прозорі смужки. І якщо деяким бактеріям для дозрівання достатньо години, іншим треба декілька діб.
Нагадаємо, що раніше експрем'єр-міністр Великої Британії Борис Джонсон позував у вишиванці з вишитим біля серця орнаментом у формі карти України в синьо-жовтих кольорах.


